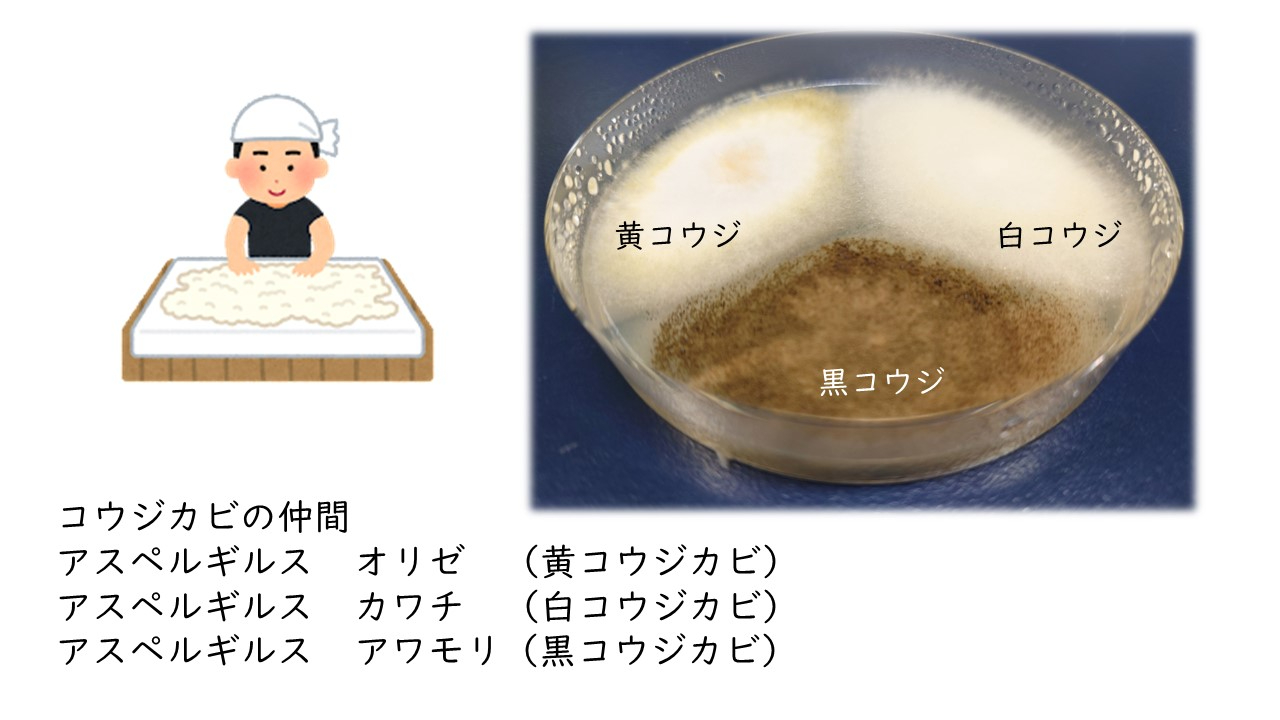
3種麹発酵食品.jpg

こんにちは
コーヒーはお好きですか?
菌を扱う仕事をしていると菌の恵みのお酒大好きな人が多く底なしで飲める人ばかり集まりなんてこともあります。
でも…私はどちらかというとコーヒー好きなんです。
残念ながらコーヒー豆などは菌の働きが関っているわけではありませんので発酵とは無縁でした。
今回OH!!!の八幡屋でコウジを使ったコーヒーを見つけたのでご紹介いたします。
コーヒーに発芽玄米麹をブレンドしているそうです。
とても甘い香りが楽しめる(麦茶の麦の甘みを思わせる)コーヒーになっています。私、個人の感想ですが自宅でいただくより、キャンプや登山、トレッキングの間にいただきたくなるようなコーヒーだと感じました。山の中でゆったりと香りとすっきりとしたのど越しが運動した後にぴったりです。
秘密を解説。
発芽玄米麴を焙煎することで適度なメイラード反応が起きて糖と麹のアミノ酸とマンナンなどの成分が香ばしくなるのではと思います。
詳しくはHPにも書いていないので仮説です。
麹はいろいろな麹を焙煎して一番的した白コウジ(学名はわかりません)を使用したそうです(HP参照)
麹もいろいろありますが個性がそれぞれあるのでなかなかベストを見つけるのは難しかったそうです。
難しい麹選びに挑戦してこのコーヒーを完成させていただいたことをコーヒー好きとしてはとっても感謝したいです。
秋が深まり(もう冬に突入していますが)登山、トレッキングなどアウトドアでぜひこのコーヒーを味わっていただけたらと思います。
今日も最後まで読んでいただきありがとうございました。